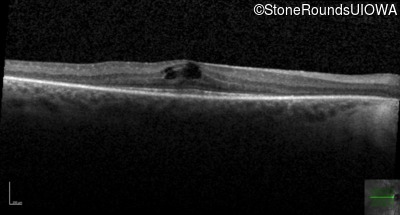
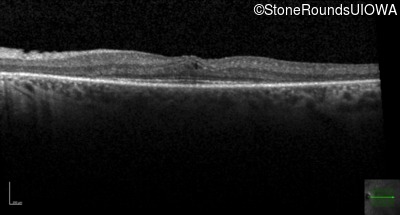
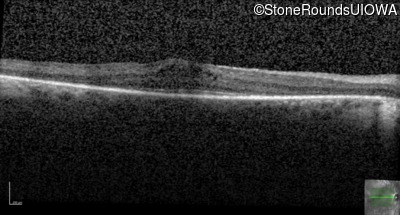
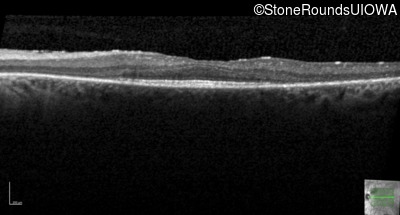
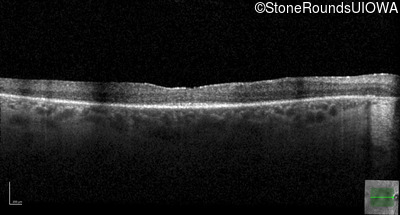
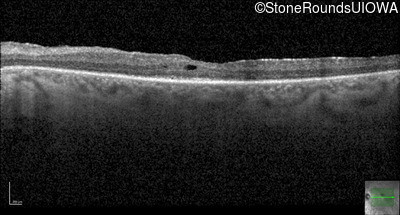
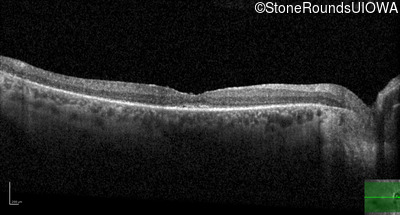
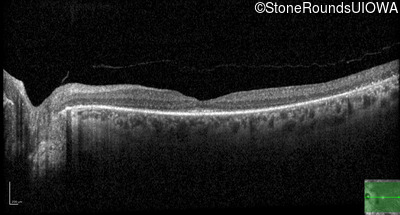

Case
SR994
Student Mode
AR Retinitis Pigmentosa (IA1aiii)
Female
Female
Hidden
SR994
Student Mode
AR Retinitis Pigmentosa (IA1aiii)
Female
Female
| Age at visit: 28 years |
| Age at visit: 29 years |
| Age at visit: 31 years |
| Age at visit: 36 years |
Diagnosis & molecular findings
| Disease | Gene | Allele 1 variant(s) | Allele 2 variant(s) | Inheritance mode |
|---|---|---|---|---|
| AR Retinitis Pigmentosa | ZNF408 | His455Tyr CAT>TAT | Arg567Stop CGA>TGA | AR |
Disease:
Gene:
Allele 1:
His455Tyr CAT>TAT
Allele 2:
Arg567Stop CGA>TGA
Inheritance:
AR